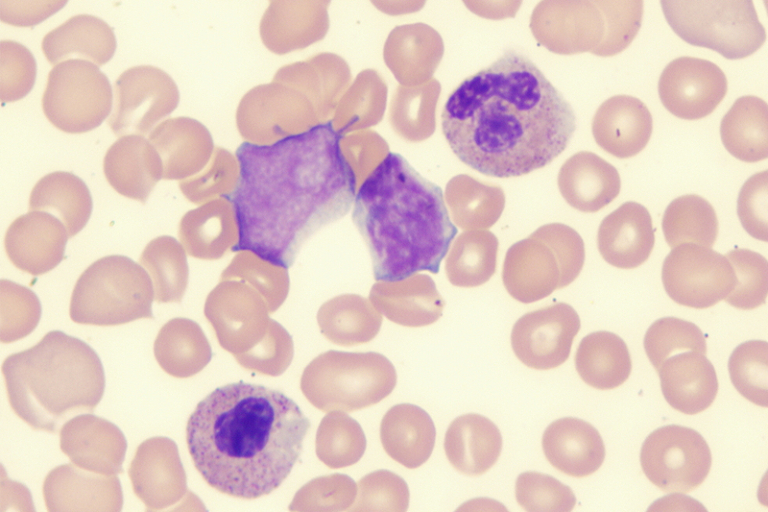

骨髓增生異常綜合症(簡稱MDS)是一種罕見血液癌症,患者血細胞無法正常成熟,嚴重影響生活質素。香港大學臨床醫學學院內科學系臨床副教授喬夏利醫生指:「大部份MDS患者均屬較低風險,又或因年長或其他因素,並不適合接受同種異體造血幹細胞移植,亦即無法治癒,他們需要長年接受各種不同的治療。」

事實上患者確診MDS後,醫生會根據患者不同血液成份數量、不正常骨髓細胞數量、年齡等作評估,劃分為非常高風險、高風險、中風險、低風險及非常低風險,根據全球數據,存活期中位數可短至0.8年(非常高風險),長至8.8年(非常低風險)。由於較高風險的患者惡化成AML機會較高,年輕及身體狀況合適的,可接受根治性的同種異體造血幹細胞移植;另有低甲基化劑或參與臨床測試試用新藥物。

輸血對患者及照顧者的影響廣泛:在健康方面,體內積聚過量鐵質可引致長期併發症;時間方面,每月需多次進出醫院,包括檢查配血及6-8小時輸血,甚至留院;感染風險方面,輸血本身有感染隱憂,加上MDS患者本已虛弱,多為長者,若受感染可致嚴重後果。

癌症資訊網慈善基金強調,現時僅有少數藥物獲資助,大部分患者需自費承擔高昂藥費,導致「財政毒性」,並加劇患者及照顧者的身心負擔。該組織主席方嘉儀表示:「MDS患者生活嚴重受限,極需適切治療以重獲新生。我們呼籲政府盡快擴大藥物資助,讓更多患者免於輸血依賴及財政負擔,提升生活質素。」基金希望透過此呼籲,促使社會大眾認識 MDS,並敦促香港政府當局關注此公共衛生議題。
延伸閱讀

